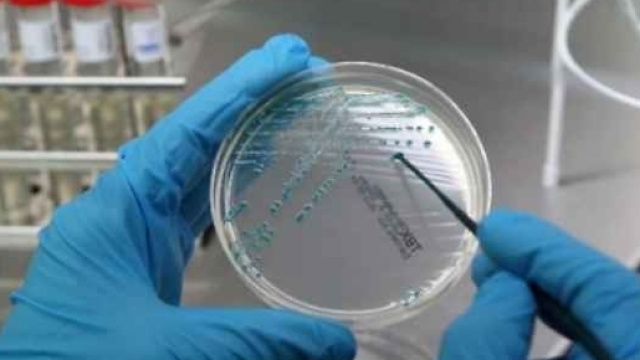
Trieste: pediatra affetta da tubercolosi vaccinava bambini.

A Trieste,una pediatra che effettuava vaccinazioni in convenzione con l'ASL locale è risultata malata di tbc.Si dovranno effettuare deicontrolli su circa 3.500 bambini, che verranno sottoposti al test della tubercolina, per accertare eventuali contagi.
A Trieste pediatra ammalata di tubercolosi
Una pediatra di Trieste, luogo in cui esercitava la sua professione in convenzione con l'ASL locale, nonostante fosse affetta da tubercolosi ha continuato a vaccinare i bambini. Premesso che non c'è molta probabilità di contagio per i piccoli pazienti, in quanto il contatto con il medico è durato solo alcuni minuti, sono stati richiamati circa 3.500 bambini che sono stati vaccinati dalla dottoressa.
Il direttore dell'Azienda Sanitaria locale, Nicola Delli Quadri, ha informato che la dottoressa prestava servizio a Trieste nei distretti 1, 2, 3, e che ora si trova all'ospedale maggiore della cittadina friulana. È ricoverata nel reparto che tratta e cura le malattie infettive. I bambini vaccinati nell'ambulatorio medico in questione hanno un'età compresa da 0 a 6 anni.
Minima la probabilità di contagio per i bimbi
Per accertarsi che tutti i piccoli pazienti vaccinati dalla dottoressa non siano stati infettati dalla tubercolosi, occorreranno dai due ai tre mesi, anche se la probabilità di contagio è minima, visto che per contrarre la malattia infettiva si dovrebbe essere esposti al contagio per almeno otto ore consecutive alla distanza di un metro da chi è ammalato.
Un numero verde è disponibile per chi pensa di avere bisogno di chiarimenti, e l'ASL ha predisposto 6 ambulatori, nei quali verranno effettuati i test della tubercolina ai piccoli pazienti. Le strutture mediche ed ospedaliere di tutta la città di Trieste, in particolarel’Ospedalepediatrico Burlo Garofalo, possono essere contattati da chi ne può avere bisogno.
Tubercolosi: malattia contagiosa da batterio
Il Mycobacterium tuberculosis, chiamato anche bacillo di Koch, causa la trasmissione del contagio che può avvenire attraverso la saliva, gli starnuti o i colpi di tosse. Non occorrono tanti batteri per essere contagiati, ed i sistemi immunitari possono contrastare l'infezione al punto che la malattia non si nota per molti anni, fino a manifestarsi all'improvviso.
Una percentuale che varia dal 10 al 15% degli infettati manifesta la malattia e può, a sua volta, contagiare una quindicina di persone all'anno. La patologia comunque si può prevenire e curare, anche se è molto temuta e la sua terapia, come la prevenzione, avviene con metodi antiquati, che risalgono a tempi antichi.
Il rischio di infettare altre persone si annulla o si riduce drasticamente se il contagiato è trattato con le dovute cure, e sicuramente si potrebbero fare molti passi in avanti se i mezzi diagnostici fossero più moderni e adeguati.